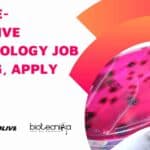
Colgate-Palmolive Microbiology Job Opening, Apply Online Colgate-Palmolive Microbiology Job

Home Search
biology - search results
If you're not happy with the results, please do another search
MSc Microbiology QC Officer Job Opening at Bharat Serums and Vaccines
MSc Microbiology QC Officer Job Opening at Bharat Serums and Vaccines
MSc Microbiology QC Officer Job Opening at Bharat Serums and Vaccines. BSV job opening...
SSS-NIBE Bio-Energy Promotion Fellowship For MSc, B.E., BTech Biochem, Microbiology, Biotech
SSS-NIBE Bio-Energy Promotion Fellowship For MSc, B.E., BTech Biochem, Microbiology, Biotech
SSS-NIBE Bio-Energy Promotion Fellowship For MSc, B.E., BTech Biochem, Microbiology, Biotech. Interested and eligible...
Jubilant Biosys Structural Biology Research Scientist Job Opening, Apply Online
Jubilant Biosys Structural Biology Research Scientist Job Opening, Apply Online
Jubilant Biosys Structural Biology Research Scientist Job Opening, Apply Online. Jubilant Biosys Limited jobs 2023....
IISER TVM Biology, Biotechnology JRF Job Opening, Applications Invited
IISER TVM Biology, Biotechnology JRF Job Opening, Applications Invited
IISER TVM Biology, Biotechnology JRF Job Opening, Applications Invited. IISER TVM is hiring Biology & Biotechnology...
CSIR-NCL MSc, BTech Bioinformatics, Biotech & Microbiology Job Openings
CSIR-NCL Bioinformatics Jobs, Biotech & Microbiology Candidates Apply
CSIR-NCL Bioinformatics Jobs, Biotech & Microbiology Candidates Apply. NCL Pune is hiring MSc, BTech bioinformatics, microbiology and...
Biotecnika Times Newsletter 18.01.2023 IMTECH PhD Admission, Colgate Microbiology Job
Biotecnika Times Newsletter 18.01.2023 IMTECH PhD Admission, Colgate Microbiology Job
CSIR-IMTECH AcSIR PhD Program Admission August 2023 Session, Apply Online
CSIR-IMTECH AcSIR PhD Program Admission August...
Colgate-Palmolive Microbiology Job Opening, Apply Online
Colgate-Palmolive Microbiology Job Opening, Apply Online
Colgate-Palmolive Microbiology Job Opening, Apply Online. MSc Microbiology Jobs. Interested and eligible applicants can check out all of the...
IIT Madras MSc Biotech, Biology, Life Sciences JRF Job Opening, Applications Invited
IIT Madras MSc Biotech, Biology, Life Sciences JRF Job Opening, Applications Invited
IIT Madras MSc Biotech, Biology, Life Sciences JRF Job Opening, Applications Invited. IIT...
Freshers Job Opening at SJRI For MSc Biotech, Life Sciences, Microbiology
Freshers Job Opening at SJRI For MSc Biotech, Life Sciences, Microbiology
Freshers Job Opening at SJRI For MSc Biotech, Life Sciences, Microbiology. MSc Biotech, Microbiology...
ICMR Non-Med Biotech, Microbiology Scientist Job With Rs. 51,000 pm Pay
ICMR Non-Med Biotech, Microbiology Scientist Job With Rs. 51,000 pm Pay
ICMR Non-Med Biotech, Microbiology Scientist Job With Rs. 51,000 pm Pay. MSc, Microbiology, Biotechnology...
RCB MSc & PhD Bioinformatics, Comp Biology, Biotech Project Associate
RCB Bioinformatics Jobs For Project Associate/Scientist
RCB Bioinformatics Jobs For Project Associate/Scientist. MSc & PhD Life Sciences project openings. Interested and eligible applicants can check...
Jubilant Biosys MSc Biology, Biotech, Mol Bio, Genetics, Life Sciences Research Job
Jubilant Biosys MSc Biology, Biotech, Mol Bio, Genetics, Life Sciences Research Job
Jubilant Biosys MSc Biology, Biotech, Mol Bio, Genetics, Life Sciences Research Job. Jubilant...
CSIR-CCMB Project Openings For Cell Biology, Molecular Biology Candidates, Apply Online
CSIR-CCMB Project Openings For Cell Biology, Molecular Biology Candidates, Apply Online
CSIR-CCMB Project Openings For Cell Biology, Molecular Biology Candidates, Apply Online. Project associate job....
UPSC Biochem, Biology, Botany & Zoology Scientist Job Openings, Apply Online
UPSC Biology, Biochem, Botany & Zoology Scientist Job Openings, Apply Online
UPSC Biology, Biochem, Botany & Zoology Scientist Job Openings, Apply Online. UPSC Recruitment Latest....
Hershey India Food Tech, Microbiology QA Job Opening, Apply Online
Hershey India Food Tech, Microbiology QA Job Opening, Apply Online
Hershey India Food Tech, Microbiology QA Job Opening, Apply Online. Postgraduate in Food/ Microbiology Senior...